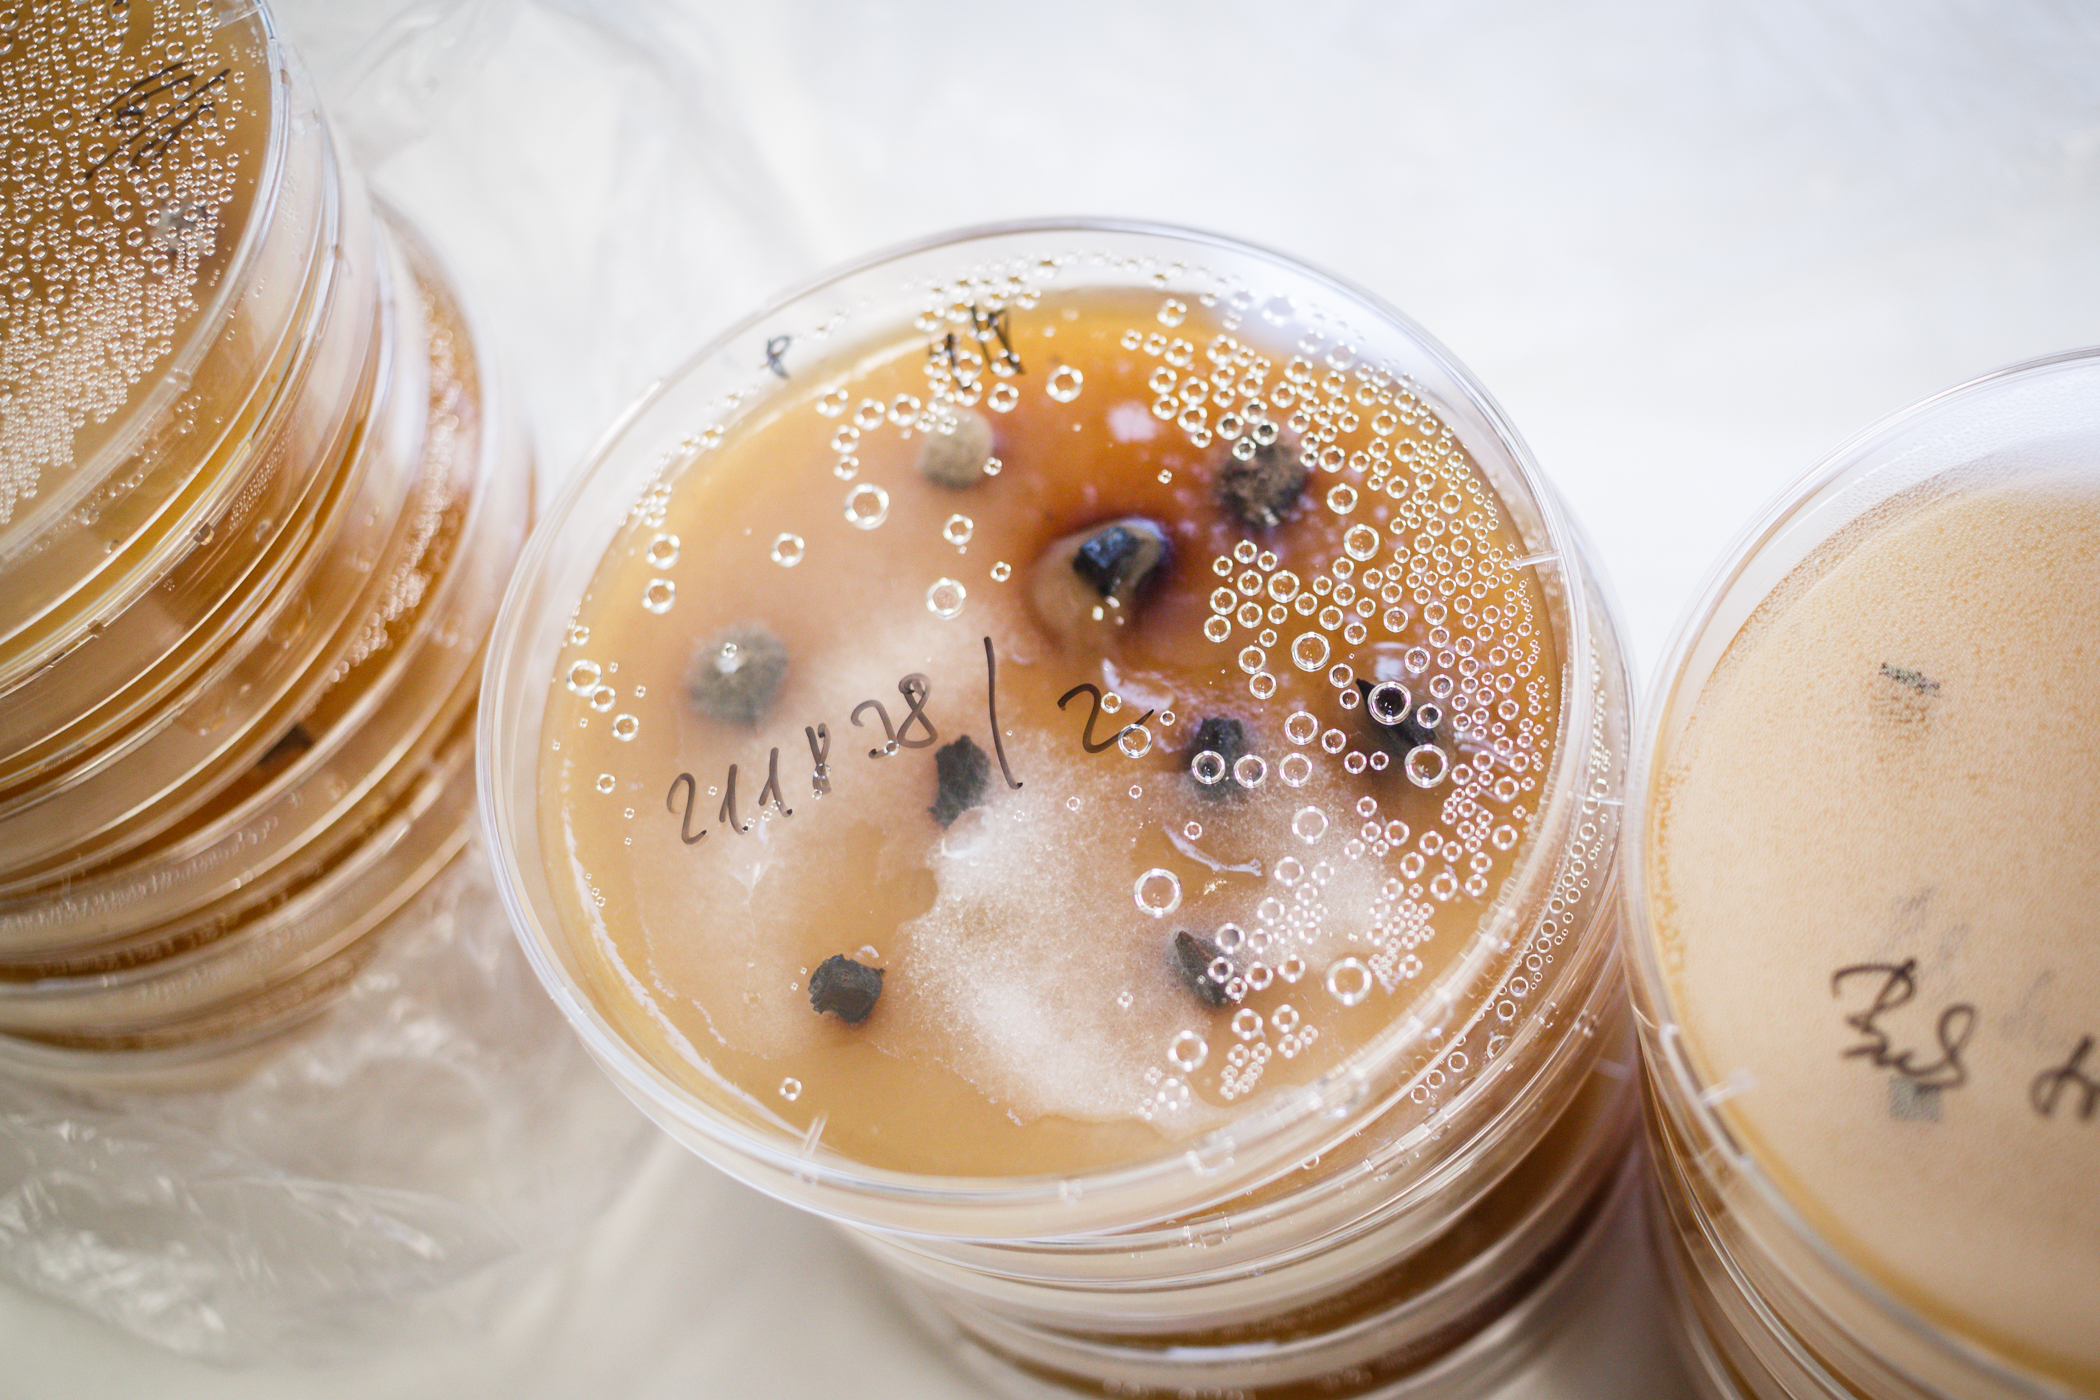

Zaměření a popis činnosti
Posláním odboru je výzkum nepůvodních invazních druhů mikroorganizmů – patogenů dřevin – nebezpečných pro životní prostředí ČR a tvorba opatření omezujících jejich dopad. Vyvíjena jsou opatření pro všechny typy vegetace a systémy zeleně od přírodních biotopů přes nejrůznější produkční porosty, výsadby mimo les až po městskou zeleň a památné stromy a na všech prostorových škálách.
Poslání je naplňováno v rámci následujících aktivit:
- Hodnocení diverzity nepůvodních zavlečených druhů, identifikace významných druhů (potenciálních transformerů), uchovávání jejich genofondu a jejich další výzkum (ekologie, epidemiologie aj.).
- Hodnocení impaktu invazí a změn v diverzitě a struktuře invadovaných porostů a společenstev, vytváření statistických modelů a vývoj predikcí pro území ČR.
- Tvorba nástrojů k omezení impaktu invazních druhů (mitigační a adaptační opatření; integrovaná ochrana), výzkum rezistence dřevin, selekce a uchovávání odolných genotypů a rezistentní šlechtění; výzkum genetické eroze dřevin, uchování genofondu dřevin.
Více na: www.invaznipatogeny.cz
Aktuality
Naši vědci mapují a uchovávají jedny z nejnebezpečnějších rostlinných patogenů světa
Do České republiky se nenápadně dostávají vysoce invazní patogeny rostlin, které mohou způsobit rozsáhlé škody v lesích, sadech i městské zeleni. Výzkumný ústav pro krajinu v Průhonicích buduje unikátní sbírku těchto organismů a zároveň přináší konkrétní doporučení, jak jejich šíření účinně bránit.
MY JSME VÚK! Rozhovor s Karlem Černým
Dnes se podíváme na práci odboru biologických rizik, který vede ve VÚKu Karel Černý. Hlavním tématem odboru je výzkum invazní fytopatogenní neobioty (tzn. invazních patogenů), jejího vlivu na přírodní prostředí a vývoj opatření, kterými je možné jej omezit.
VÚK hostil odborný workshop na téma zachování topolu černého v české krajině
Výzkumný ústav pro krajinu ve spolupráci s partnery Lesoškolky s. r. o. a Povodí Vltavy, s. p., uskutečnil 10. listopadu 2025 ve Vzdělávacím a informačním centru Floret v Průhonicích odborný workshop na téma Topol černý a jeho využití ve vodohospodářství a lesnictví.
Vedoucí odboru

Mgr. Karel Černý, Ph.D.
E-mail: karel.cerny@vuk.gov.cz
Telefon: 734 586 583
Pracoviště odboru: Průhonice
Projekty
Kompost jako klíč k živé půdě
Výsledky pokusů Výzkumného ústavu pro krajinu (VÚK) ukazuje, že správně připravené komposty mohou zásadně zlepšit kvalitu půdy, nahradit část minerálních hnojiv a výrazně podpořit růst rostlin – včetně lesních školek. Klíčem je jejich složení a správné dávkování.
Naši vědci mapují a uchovávají jedny z nejnebezpečnějších rostlinných patogenů světa
Do České republiky se nenápadně dostávají vysoce invazní patogeny rostlin, které mohou způsobit rozsáhlé škody v lesích, sadech i městské zeleni. Výzkumný ústav pro krajinu v Průhonicích buduje unikátní sbírku těchto organismů a zároveň přináší konkrétní doporučení, jak jejich šíření účinně bránit.
Unikátní sbírka VÚK láká na téměř stoletou tradici šlechtění rododendronů v Průhonicích
Květná sezóna pěnišníků (rododendronů a azalek) je ve Výzkumném ústavu pro krajinu (VÚK) v plném proudu. V Dendrologické zahradě v Průhonicích nyní postupně rozkvétá množství keřů a návštěvníci mohou obdivovat přibližně tisíc genotypových položek – od planých druhů k historickým až po moderní odrůdy včetně výsledků vlastního průhonického šlechtění. Kolekce pěnišníku, kterou spravuje Dendrologická zahrada VÚK, patří mezi nejvýznamnější svého druhu ve střední Evropě a navazuje na více než sto let trvající tradici jejich pěstování v Průhonicích.





